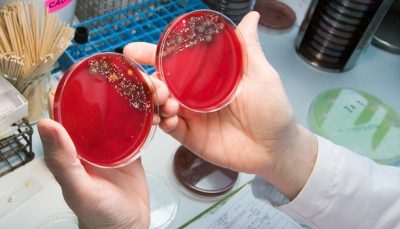

Описание возбудителя, этиология и патогенез
Чтобы разобраться, как лечить уреаплазмоз, важно сначала понять, что это за заболевание. Уреаплазмоз вызывается граммотрицательной бактерией, которая не имеет клеточной мембраны и ДНК. Эта бактерия способна взаимодействовать с эпителием мочеполовых органов и занимает промежуточное положение между одноклеточными паразитами и вирусами.
Она может находиться в организме человека на протяжении многих лет, не вызывая никаких симптомов. В большинстве случаев заболевание протекает в хронической форме, оставаясь незамеченным.
Основные факторы, способствующие возникновению воспалительных процессов:
- Изменения в гормональном фоне, как физиологические, так и патологические (например, беременность или нарушения в работе яичников).
- Снижение иммунной функции. Уменьшается количество клеток, способных уничтожать возбудителя, что приводит к снижению резистентности организма.
- Дисбаланс микрофлоры влагалища, вызванный стрессом, беременностью или приемом антибиотиков.
- Гинекологические вмешательства (такие как аборт или цистоскопия), которые могут спровоцировать воспалительные процессы и, как следствие, уреаплазмоз у женщин.
- Наличие возбудителя у полового партнера. Бактерия может передаваться вместе с другими инфекциями, передающимися половым путем.
Когда бактерия попадает во влагалище, она связывается с эпителием слизистой оболочки, проникает в цитоплазму клеток и начинает размножаться. Паразит выделяет ферменты, которые атакуют иммунную систему, что приводит к снижению уровня иммуноглобулина A.
Если заболевание имеет хронический характер, возбудитель остается неактивным, и структура клеток не претерпевает изменений. Однако в острую фазу начинается воспалительный процесс, сосудистая реакция и разрушение клеток эпителия. Увеличивается проницаемость сосудов, что вызывает отек.
Врачи отмечают, что уреаплазмоз у женщин может представлять определенную опасность, особенно если заболевание не диагностируется и не лечится вовремя. Уреаплазмы — это микроорганизмы, которые могут вызывать воспалительные процессы в мочеполовой системе. Врачи подчеркивают, что уреаплазмоз часто протекает бессимптомно, что делает его особенно коварным. При отсутствии лечения инфекция может привести к серьезным осложнениям, таким как воспаление органов малого таза, бесплодие и повышенный риск преждевременных родов. Специалисты рекомендуют регулярные обследования и консультации с врачом для своевременного выявления и лечения инфекции. Важно помнить, что ранняя диагностика и адекватная терапия могут значительно снизить риски и сохранить здоровье.

Пути заражения
- От матери к ребенку (при прохождении через родовые пути и плаценту). Чаще всего заражаются девочки, чем мальчики. У новорожденных симптомы не проявляются. В таких случаях возможно естественное выздоровление.
- Половой путь (наиболее распространенный). Инфекция передается через биологические жидкости организма (сперма, вагинальные выделения, секрет простаты), содержащие возбудителя. Многие люди не подозревают о своем заражении, что увеличивает риск передачи инфекции.
Поскольку у этой бактерии отсутствует мембрана, она теряет свои патогенные свойства в окружающей среде и разрушается, поэтому контактно-бытовой путь передачи исключен. Это также касается и бассейнов.
Понимая, как происходит передача данной инфекции, а также других заболеваний, передающихся половым путем, человек может защитить себя и свою семью от заражения.
В зависимости от выраженности клинических проявлений и характера течения болезни выделяют:
- носительство возбудителя (симптомов и воспалительных процессов нет);
- острая форма: поражение слизистой, симптомы интоксикации (встречается редко);
- хроническая форма: воспаление может возникнуть под воздействием стрессовых факторов, возможны осложнения, такие как воспаление яичников, матки и бесплодие.
| Симптом | Опасность | Что делать |
|---|---|---|
| Отсутствие симптомов | Может протекать бессимптомно, но при этом вызывать воспалительные процессы в репродуктивной системе, повышая риск бесплодия и внематочной беременности. | Регулярные профилактические осмотры у гинеколога, сдача анализов на ИППП. |
| Выделения из влагалища (измененный цвет, запах, консистенция) | Указывает на воспаление, может привести к развитию вагинита, цервицита, сальпингита. | Обращение к врачу для диагностики и лечения. |
| Боль внизу живота | Может свидетельствовать о воспалении внутренних половых органов, потенциально угрожающее бесплодием. | Немедленное обращение к врачу. |
| Болезненные мочеиспускания | Уреаплазма может поражать мочевыводящие пути, вызывая уретрит. | Обращение к врачу для диагностики и лечения. |
| Боль во время полового акта | Может быть признаком воспаления шейки матки или других органов репродуктивной системы. | Обращение к врачу для диагностики и лечения. |
| Нарушение менструального цикла | В редких случаях может быть связано с воспалительным процессом. | Консультация гинеколога. |
| Бесплодие | Уреаплазмоз может стать причиной воспалительных процессов, приводящих к закупорке маточных труб и бесплодию. | Лечение уреаплазмоза, поддержка фертильности. |
| Внематочная беременность | Воспаление, вызванное уреаплазмой, повышает риск внематочной беременности. | Лечение уреаплазмоза, тщательное наблюдение во время беременности. |
Симптомы
Чаще всего встречается хроническая форма инфекции, при которой симптомы отсутствуют. Признаки уреаплазмоза у женщин проявляются в моменты обострения и представляют собой симптомы воспалительного процесса в мочеполовой системе.
Жалобы, возникающие в острую фазу:
- прозрачные выделения;
- жжение и зуд;
- дискомфорт в области паха;
- болезненные ощущения при мочеиспускании;
- тяжесть в нижней части живота.
Факторы, способствующие заражению и развитию заболевания:
- длительный стресс;
- ослабление иммунной системы;
- дисбаланс микрофлоры влагалища;
- наличие сопутствующих инфекций;
- неправильное питание;
- несоблюдение личной гигиены;
- использование антибиотиков;
- беременность.
Уреаплазмоз — это инфекция, вызванная микроорганизмами рода Ureaplasma, которая может поражать мочеполовую систему женщин. Многие женщины, столкнувшиеся с этой проблемой, отмечают, что симптомы могут быть неочевидными, что затрудняет диагностику. Некоторые жалуются на дискомфорт, зуд или выделения, но у многих инфекция протекает бессимптомно. Важно понимать, что уреаплазмоз может привести к серьезным осложнениям, таким как воспаление органов малого таза, бесплодие и повышенный риск инфекций во время беременности. Поэтому регулярные обследования и консультации с врачом крайне важны. Многие специалисты подчеркивают, что своевременное лечение может предотвратить негативные последствия и сохранить здоровье.

Осложнения
Уреаплазмоз может вызвать ряд серьезных последствий:
- У женщин: воспалительные процессы в органах малого таза, бесплодие.
- У мужчин: бесплодие.
- Во время беременности: риск выкидыша, преждевременные роды, хроническое невынашивание, плацентарная недостаточность.
- У плода: возможные нарушения в развитии.
- У новорожденного: ослабление иммунной системы, частые заболевания.
Важно своевременно диагностировать уреаплазмоз перед планированием беременности, поскольку в этот период женщинам нельзя использовать многие медикаменты.
Диагностика
При обследовании влагалища женщины, врач не сможет установить точный диагноз, даже если имеются клинические симптомы. Поэтому важно проводить лабораторные исследования.
- ПЦР. Это наиболее достоверный анализ, который позволяет определить вид паразита и его количество. Генетический материал может быть обнаружен в течение 1-2 суток.
- Посев на питательной среде необходим для оценки чувствительности к антибиотикам.
- Серологические тесты помогают выявить наличие антител к инфекции в крови.
Перед сдачей анализов следует придерживаться следующих рекомендаций врача:
- не использовать медикаменты, которые могут повлиять на результаты (антибиотики, антисептики);
- избегать спринцевания и применения свечей;
- воздержаться от половых контактов;
- перед анализом рекомендуется принять душ;
- если необходимо продолжать прием какого-либо препарата, обязательно сообщите об этом врачу.
Дифференциальная диагностика уреаплазмоза включает в себя такие заболевания, как кандидоз, бактериальный вагиноз и трихомониаз. Эти состояния различаются по характеру влагалищных выделений, их запаху и дискомфортным ощущениям у женщины.
Также важно отличать уреаплазму от хламидий, микоплазмы и гонококков. Это возможно только с помощью метода ПЦР, который позволяет распознать генетическую структуру каждого из этих микроорганизмов.

Лечение
Полное избавление от заболевания представляет собой сложную задачу, так как паразит зачастую остается в клетках организма в неактивном состоянии, периодически вызывая обострения. Важно предпринять шаги для восстановления микрофлоры и укрепления иммунной системы. Рекомендуется обратиться к гинекологу, который даст рекомендации по лечению данного типа инфекций, передающихся половым путем.
Специалист может использовать следующие методы терапии:
- Антибактериальная терапия. Для минимизации воздействия на иммунную систему назначаются препараты местного действия, такие как вагинальные свечи и таблетки. Курс лечения длится от 10 до 14 дней, в зависимости от уровня инфекции. В этом случае могут быть использованы макролиды и тетрациклины. Поскольку часто наблюдается одновременное наличие нескольких инфекций, применяются препараты широкого спектра действия.
- Противогрибковые средства (вагинальные или системные). Их использование необходимо, так как антибиотики могут способствовать росту грибков рода Candida.
- Пробиотики, которые помогают восстановить флору влагалища. Их следует принимать в течение одного-двух месяцев до полного восстановления.
- Иммуномодуляторы.
- Энзимы, которые помогают уменьшить воспаление.
- Витамины.
- Сидячие ванночки с лечебными травами, которые помогут облегчить зуд и воспаление. Спринцевание лучше избегать, так как это может привести к распространению инфекции вверх к матке. Рекомендуются отвары ромашки, корня солодки и коры дуба.
Если симптомы отсутствуют, лечение должно быть направлено на уменьшение воспалительного процесса. Антибиотики применяются в остром периоде или при планировании беременности.
Это связано с тем, что инфекция не всегда полностью излечивается, и при частом использовании противомикробных препаратов у паразитов может развиться резистентность. Важно следовать назначенной схеме лечения, так как отсутствие препаратов, защищающих микрофлору, может привести к осложнениям, таким как кандидоз.
Чтобы убедиться в эффективности назначенного гинекологом препарата, можно посетить женский форум, где представлено множество отзывов о применяемых лекарствах и других методах лечения заболевания.
Прогноз и профилактика
После завершения терапии организм восстанавливается полностью. Однако, учитывая, что возбудитель широко распространен среди людей, существует вероятность повторного заражения. Чтобы избежать этого, важно использовать средства защиты во время половых актов. Также стоит обратить внимание на правильное питание, избегать стрессов и обеспечивать себе полноценный сон.
Каждой женщине рекомендуется проходить обследование у гинеколога не реже одного раза в год. После лечения уреаплазмоза необходимо повторно сдать анализы. При планировании беременности важно пройти тест на наличие инфекций, передающихся половым путем.
Вопрос-ответ
Что такое уреаплазмоз и как он передается?
Уреаплазмоз — это инфекционное заболевание, вызванное бактериями рода Ureaplasma. Оно может передаваться половым путем, а также возможно заражение при контакте с инфицированными предметами или через родовые пути от матери к ребенку.
Какие симптомы могут указывать на уреаплазмоз у женщин?
Симптомы уреаплазмоза могут варьироваться, но часто включают жжение или зуд в области половых органов, болезненное мочеиспускание, выделения из влагалища и дискомфорт во время полового акта. Однако у многих женщин заболевание может протекать бессимптомно.
Как уреаплазмоз влияет на репродуктивное здоровье?
Уреаплазмоз может привести к различным осложнениям, таким как воспалительные заболевания органов малого таза, бесплодие и повышенный риск преждевременных родов. Поэтому важно своевременно диагностировать и лечить это заболевание.
Советы
СОВЕТ №1
Регулярно проходите медицинские обследования. Уреаплазмоз может протекать бессимптомно, поэтому важно регулярно посещать гинеколога для профилактических осмотров и анализов.
СОВЕТ №2
Обратите внимание на симптомы. Если вы заметили изменения в менструальном цикле, болезненные ощущения или необычные выделения, не откладывайте визит к врачу, так как это может быть признаком инфекции.
СОВЕТ №3
Соблюдайте правила личной гигиены. Используйте средства интимной гигиены, избегайте случайных половых связей и всегда используйте презервативы для снижения риска передачи инфекций.
СОВЕТ №4
Не занимайтесь самолечением. Если у вас диагностирован уреаплазмоз, следуйте рекомендациям врача и не пытайтесь лечиться самостоятельно, так как это может привести к осложнениям.